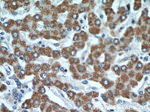
GOT2 Antibody in Immunohistochemistry (Paraffin) (IHC (P))

Search
Proteintech
GOT2 Polyclonal Antibody
{{$productOrderCtrl.translations['antibody.pdp.commerceCard.promotion.promotions']}}
{{$productOrderCtrl.translations['antibody.pdp.commerceCard.promotion.viewpromo']}}
{{$productOrderCtrl.translations['antibody.pdp.commerceCard.promotion.promocode']}}: {{promo.promoCode}} {{promo.promoTitle}} {{promo.promoDescription}}. {{$productOrderCtrl.translations['antibody.pdp.commerceCard.promotion.learnmore']}}
产品信息
14800-1-AP
种属反应
已发表种属
宿主/亚型
分类
类型
抗原
偶联物
形式
浓度
规格
纯化类型
保存液
内含物
保存条件
运输条件
产品详细信息
Immunogen sequence: KAEAQIAAK NLDKEYLPIG GLAEFCKASA ELALGENSEV LKSGRFVTVQ TISGTGALRI GASFLQRFFK FSRDVFLPKP TWGNHTPIFR DAGMQLQGYR YYDPKTCGFD FTGAVEDISK IPEQSVLLLH ACAHNPTGVD PRPEQWKEIA TVVKKRNLFA FFDMAYQGFA SGDGDKDAWA VRHFIEQGIN VCLCQSYAKN MGLYGERVGA FTMVCKDADE AKRVESQLKI LIRPMYSNPP LNGARIAAAI LNTPDLRKQW LQEVKVMADR IIGMRTQLVS NLKKEGSTHN WQHITDQIGM FCFTGLKPEQ VERLIKEFSI YMTKDGRISV AGVTSSNVGY LAHAIHQATK (82-430 aa encoded by BC000525)
靶标信息
GOT2 is a glutamic-oxaloacetic transaminase is a pyridoxal phosphate-dependent enzyme which exists in cytoplasmic and inner-membrane mitochondrial forms, GOT1 and GOT2, respectively. GOT plays a role in amino acid metabolism and the urea and tricarboxylic acid cycles. The two enzymes are homodimeric and show close homology.
仅用于科研。不用于诊断过程。未经明确授权不得转售。
生物信息学
蛋白别名: aspartate aminotransferase 2; aspartate aminotransferase precursor (2.6.1.1); Aspartate aminotransferase, mitochondrial; aspartate transaminase 2; FABP-1; FABPpm; Fatty acid-binding protein; FLJ40994; Glutamate oxaloacetate transaminase 2; glutamate oxaloacetate transaminase 2, mitochondrial; Glutamate oxaloacetate transaminase 2, mitochondrial (aspartate aminotransferase 2); glutamic-oxaloacetic transaminase 2, mitochondrial; glutamic-oxaloacetic transaminase 2, mitochondrial (aspartate aminotransferase 2); Kynurenine aminotransferase 4; Kynurenine aminotransferase IV; Kynurenine--oxoglutarate transaminase 4; Kynurenine--oxoglutarate transaminase IV; mAspAT; mitochondrial aspartate aminotransferase; plasma membrane fatty acid binding protein; Plasma membrane-associated fatty acid-binding protein; Transaminase A; unnamed protein product
基因别名: AL022787; ASPATA; DEE82; FABP-pm; Got-2; GOT2; KAT4; KATIV; KYAT4; Maat; mAspAT; mitAAT
UniProt ID: (Human) P00505, (Mouse) P05202, (Rat) P00507
Entrez Gene ID: (Human) 2806, (Mouse) 14719, (Rat) 25721